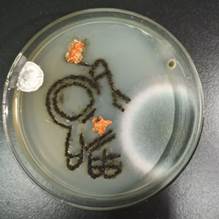
QQ圖片20221013212017.jpg

為進一步貫徹落實《中華人民共和國科學技術普及法》和《全民科學素質行動規劃綱要 (2021- 2035年)》,動員和激勵廣大青年學生參與科普創作,進一步推動微生物學知識科普,展示微生物多姿多彩的“微”美世界,促進科學、人文與藝術融合,涵養大學生審美情趣,激發大學生鉆研生命科學的志趣,提升大學生科研實踐能力,增強大學生創新精神,經研究決定,由湖北省科學技術協會和華中農業大學主辦,華中農業大學生命科學技術學院和華中農業大學現代生命科學技術科普基地承辦,湖北省微生物學會和武漢微生物學會協辦了湖北省第一屆微生物培養皿藝術設計大賽。
本屆比賽的主題為:科學探索“微”之美,青春獻禮二十大。參賽團隊依據大賽主題,通過微生物培養技術在培養皿上進行藝術創作,使在培養基上生長的、表達不同顏色的微生物組成各種各樣積極向上的正能量圖案;同時需對相關微生物的種類、生長情況、顏色情況等進行科學研究,以更好地利用微生物進行藝術創作,形成創意細菌畫作品。大賽主要考察參賽團隊的微生物基本知識、基本實驗操作能力和研究能力、藝術設計和創造能力等。
全省22所高校,近千支隊伍,提交了839份作品。組委會組織了包括湖北省科協、湖北美術學院、武漢大學、中科院病毒所、中國地質大學、華中農業大學在內的專家對作品進行了兩輪評審,優中選優,最終評選出了一等獎3個、二等獎8個、三等獎14個、優秀獎90個,并對本次比賽中表現突出的高校和教師予以表彰。
我院共有近50支隊伍參加該競賽,其中夏爽和李曉華老師指導創作的作品《剪紙系列·中國紅》獲得二等獎(圖1),閻春蘭老師指導創作的《啟程,向前所未有的高度》獲三等獎,另有四支隊伍獲得優秀獎(見表1);中南民族大學獲優秀組織獎,3名指導教師獲優秀指導教師。
表1 本校獲獎項目匯總
|
項目名稱 |
參賽學生 |
指導教師 |
獲獎獎項 |
1 |
剪紙系列·中國紅 |
周貽馨,郭晨雨,霍莉 |
夏爽,李曉華 |
二等獎 |
2 |
啟程,向前所未有的高度 |
李瀟瀟,歐海麗,周雨佳 |
閻春蘭 |
三等獎 |
3 |
“微”以“生”力,喜迎20大 |
周茹,常遠嬌,涂力心 |
祝偉,聶麗 |
優秀獎 |
4 |
希望 |
唐可,尹晗,施冬青 |
湛蔚 |
優秀獎 |
5 |
鳳凰花開 |
馬佳帥,易天志,李遠婷 |
李曉華 |
優秀獎 |
6 |
梅香如故 |
潘盈盈,王晨彬,楊雪娟 |
閻春蘭,丁穎 |
優秀獎 |


圖1 剪紙系列·中國紅 左為《剪紙·繁榮紅》, 右為《剪紙·團結紅》
《剪紙·繁榮紅》圖樣是被譽為“花中之王”的國花牡丹,表達對祖國繁榮昌盛,實現中華民族偉大復興的美好祝福。《剪紙·團結紅》圖樣為似火的石榴。黨的十八大以來,“各民族像石榴籽一樣緊緊抱在一起”已經深入人心,成為各族人民團結一致推進中華民族共同體建設,踔厲奮發實現中華民族偉大復興的鮮明標識。鑄牢中華民族共同體意識,各民族共同團結奮斗,共同繁榮發展。

圖2 啟程,向前所未有的高度 左圖:火箭發射;中圖:遨游太空;右圖:初見月球
《火箭發射》以蠟筆畫的形式,展現中國航天火箭升空的景象!“地球上人和人硬碰硬,太空里有火箭與星星打交道,碰落一身星光。”這一定是當時航天工作者心中最想看到的畫面,此作品向他們致敬,向他們的夢想致敬。《遨游太空》以宇宙為背景,近處是地球,遠處為月球,手持中國國旗和帶著紅星的宇航員順利進入太空,遨游漫步。這一步承載著億萬中國人千百年的夢,我們向宇航員致敬,向中國夢致敬。《初見月球》還原了嫦娥一號拍攝的第一幅月面圖像,展示了從月球視角處拍攝的月球與遠處的地球,代表著中國探月工程正式開啟。

圖3 “微”以“生”力,喜迎20大
本作品以二十大作為背景貫穿全作,運用了青年、黨徽、稻穗、天安門、中國夢等元素,將投身于祖國的人民與黨和實現偉大的中國夢相連,串成了一個小的故事。并以滅菌竹簽和粗端牙簽為畫筆,以金黃色葡萄球菌、未知紅色菌種和大腸桿菌為顏料,在普通LB培養基上逐步創作而成。

圖4 希望
該作品秉承“糧安天下,黨鑄基石”的理念,以慶祝祖國華誕,喜迎二十大并致敬革命前輩們以及長期以來嘔心瀝血的科學家們為創意原點進行構思。經過悉心設計,以滅菌細毛筆、接種環為畫筆,以大腸桿菌和金黃色葡萄球菌為顏料,在LB培養基上通過刻紙印畫創作而成。

圖5 鳳凰花開
該作品秉承“奮進新征程,建功新時代”的理念,依據鳳凰花主體象征社會主義的紅旗迎風飄揚的創意構想。以接種環和無菌棉簽為畫筆,以紅色靈桿菌,金黃色葡萄球菌等菌落產的色素為顏料,再經過恒溫培養在LB培養基上依靠菌落自身形狀特征逐步創作而成。


圖6 梅香如故
該作品秉承“矢志不渝、為國奉獻”的民族精神,依據在遵義的小樓里,在偉大領袖毛澤東的帶領下,共產黨人重整旗鼓,為新篇章的到來寫下序言為創意原點進行構思。經過悉心設計,以滅菌棉簽、粗端牙簽為畫筆,大腸桿菌和在土壤里篩選出的紅色未知菌等菌種為顏料,在特制調色、漸變渲染的牛肉膏蛋白胨培養基上逐步創作而成。



